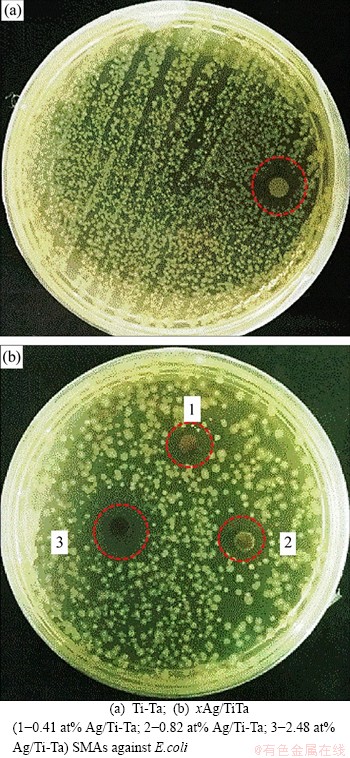

Role of Ag addition on microstructure, mechanical properties, corrosion behavior and biocompatibility of porous Ti-30 at%Ta shape memory alloys
来源期刊:中南大学学报(英文版)2020年第11期
论文作者:Mustafa Khaleel IBRAHIM Safaa Najah SAUD Esah HAMZAH Engku Mohamad NAZIM
文章页码:3175 - 3187
Key words:porous xAg/Ti-Ta; shape memory alloys (SMAs); microwave sintering process; microstructure characteristics; mechanical properties and corrosion behavior; bioactivity
Abstract: In the present study, the thermal, mechanical, and biological properties of xAg/Ti-30Ta (x=0, 0.41, 0.82 and 2.48 at%) shape memory alloys (SMAs) were investigated. The study was conducted using optical and scanning electron microscopy (SEM), X-ray diffractometry (XRD), compression test, and shape memory testing. The xAg/Ti-Ta was made using a powder metallurgy technique and microwave-sintering process. The results revealed that the addition of Ag has a significant effect on the pore size and shape, whereas the smallest pore size of 11 μm was found with the addition of 0.41 at% along with a relative density of 72%. The fracture stress and strain increased with the addition of Ag, reaching the minimum values around 0.41 at% Ag. Therefore, this composition showed the maximum stress and strain at fracture region. Moreover, 0.82 Ag/Ti-Ta shows more excellent corrosion resistance and biocompatibility than other percentages, obtaining almost the same behaviour of the pure Ti and Ti?6Al?4V alloys, which can be recommended for their promising and potential response for biomaterial applications.
Cite this article as: Mustafa Khaleel IBRAHIM, Safaa Najah SAUD, Esah HAMZAH, Engku Mohamad NAZIM. Role of Ag addition on microstructure, mechanical properties, corrosion behavior and biocompatibility of porous Ti-30 at%Ta shape memory alloys [J]. Journal of Central South University, 2020, 27(11): 3175-3187. DOI: https://doi.org/10.1007/s11771-020-4539-z.

J. Cent. South Univ. (2020) 27: 3175-3187
DOI: https://doi.org/10.1007/s11771-020-4539-z

Mustafa Khaleel IBRAHIM1, 3, Safaa Najah SAUD2, Esah HAMZAH3, Engku Mohamad NAZIM3
1. Faculty of Computer Engineering, University of Imam Jafar Sadeq Maysan Branch, Maysan 62012, Iraq;
2. Faculty of Information Sciences and Engineering, Management & Science University,40100 Shah Alam, Selangor, Malaysia;
3. Faculty of Mechanical Engineering, Universiti Teknologi Malaysia, 81310 UTM Johor Bahru,Johor, Malaysia
Central South University Press and Springer-Verlag GmbH Germany, part of Springer Nature 2020
Abstract: In the present study, the thermal, mechanical, and biological properties of xAg/Ti-30Ta (x=0, 0.41, 0.82 and 2.48 at%) shape memory alloys (SMAs) were investigated. The study was conducted using optical and scanning electron microscopy (SEM), X-ray diffractometry (XRD), compression test, and shape memory testing. The xAg/Ti-Ta was made using a powder metallurgy technique and microwave-sintering process. The results revealed that the addition of Ag has a significant effect on the pore size and shape, whereas the smallest pore size of 11 μm was found with the addition of 0.41 at% along with a relative density of 72%. The fracture stress and strain increased with the addition of Ag, reaching the minimum values around 0.41 at% Ag. Therefore, this composition showed the maximum stress and strain at fracture region. Moreover, 0.82 Ag/Ti-Ta shows more excellent corrosion resistance and biocompatibility than other percentages, obtaining almost the same behaviour of the pure Ti and Ti-6Al-4V alloys, which can be recommended for their promising and potential response for biomaterial applications.
Key words: porous xAg/Ti-Ta; shape memory alloys (SMAs); microwave sintering process; microstructure characteristics; mechanical properties and corrosion behavior; bioactivity
Cite this article as: Mustafa Khaleel IBRAHIM, Safaa Najah SAUD, Esah HAMZAH, Engku Mohamad NAZIM. Role of Ag addition on microstructure, mechanical properties, corrosion behavior and biocompatibility of porous Ti-30 at%Ta shape memory alloys [J]. Journal of Central South University, 2020, 27(11): 3175-3187. DOI: https://doi.org/10.1007/s11771-020-4539-z.
1 Introduction
Shape memory alloys (SMAs) and nickel-titanium (NiTi) alloys are now widely used for biomedical applications due to their vital and attractive characteristics [1]. They are able to recover their unreformed shape after unloading and to experience an explicit phenomenon known as pseudoelasticity (PE). These materials are also capable of maintaining the shape deformation via implementing the heating induced recovery to recall their original shape, utilizing a phenomenon called shape memory effect (SME). On the other hand, the hypersensitivity of Ni to the toxicity significantly influences the Ti-Ni alloy practises [2]. To achieve an absolute safety for the biomedical application, therefore, replacing the Ni with high potential and biocompatible elements such as Ta or Nb is essential [3-5].
The Ti alloys within β-type were recognized to performance the martensitic transformation from the disordered body centered cubic (BCC) phase (β) to hexagonal (a′) or orthorhombic martensite (a″) metastable martensite structures by quenching process. Due to control of the alloying elemental contents, the structure of martensitic phase can be changed from a′ to a″ phase [6]. In addition, during the transformation from β to a″, the resulted strain is primarily induced by the internal twinning and the SME is resulted as an inverse transformation from a″ to β phase when the applied temperature is increased to above the austenite finish temperature (Af), wherein the alloying element as an individual or binary addition primarily regulates this temperature. Based on the recent implementation of the modified Ti-based shape memory alloys, it has been reported that Ti-Nb [7, 8], Ti-Mo [9, 10] and Ti-V [11] alloys can induce shape memory effect. However, in Ti-Nb, low shape recovery is considered to be obtained due to the low critical stress induced by a slipping mechanism [12]. Ti-Mo is susceptible to ω phase embrittlement. At the same time, V was found to be highly cytotoxic element [13]. Therefore, the Ti-Ta alloys display an immense potential for biomedical uses due to their good SME, good corrosion resistance, and low modulus [14-16]. In addition, the SME and PE of Ti-Ta SMAs can be enhanced by thermo- mechanical treatment and alloying elements [14, 17-20]. According to the previous studies, it was stated that the Ag addition to the Ti-alloys could recuperates the strength and corrosion resistance of titanium. However, considering the increment adding more than 1 at% has given drawbacks on the fracture strength and corrosion features [21]. In contrast, the antibacterial properties were improved by increasing the silver content as well as particle size [21, 22]. Furthermore, another study was reported that Ag incorporation to Ti-Ni alloy with grain sizes ranging from tens of nanometres to micrometres, enhances the tensile strength and antibacterial effect [23]. The presence of pores in titanium alloys can reduce the elastic module [24-26] and therefore reduce the impact of “stress shielding” caused by large module elastic, which leads to a mismatch between implant materials and hard tissue with the elastic modulus of 100 and 20 GPa, respectively. This “stress shielding” will absorb, release and eventually lead to implantation failure of these kinds of hard tissues [27-29]. It is critical for the use of powder metallurgy that nearly integrated parts can be produced without deformation or machining operations [30-32]. Many researchers have been working on the transformational properties of powder metallurgy (PM)-made Ti-based alloy, which are sintered by various kinds of sintering techniques [33, 34]. The approach to microwave sintering has several key aspects contrary to the usual sintering methods. The method minimizes energy consumption, speeds heating, minimizes sintering time, improves elemental diffusion and physical and mechanical properties [35]. However, mechanical characteristics, such as form ability and ductility, are affected by the control of pores, distribution of pore, structure, precipitate formations, grain size and morphology of current phases. Thus, this study aims to improve the Ti-Ta SMAs for biomedical applications through the additions of different percentages of Ag and to accompany with a microwave sintering technique.
2 Experimental procedure
The ternary alloys of titanium, tantalum, and silver with particle size and purity of 150 μm (99.95%), 45 μm (99.5%), and 45 μm (99.9%), respectively, were prepared by a powder metallurgy technique. The metal elements were mixed using a planetary ball mill (PM100) at 300 r/min for 1 h with a ratio of 4:1. The green samples of xAg/Ti-Ta (at%) were compacted into the dimensions of Φ25 mm×10 mm using a 22.5 MPa uniaxial pressure for 5 min. The green samples were sintered via microwave sintering branded to HAMiLab-V3, Synotherm Corp, with heating up to 900 °C for 30 min. The implementing heating rate was 30 °C/min with maintaining a cooling rate of 8-9 °C/min until reaching (260±20) °C, and the samples were water quenched subsequently. According to the ASTM E9-09 standard, the sintered xAg/Ti-Ta samples were cut into 10 mm× 10 mm×20 mm via electrical discharge machining (EDM) for the purpose of compression and shape memory tests. Dimensions of Φ13.5 mm×2 mm and Φ5 mm×1.5 mm were utilized for the corrosion and antibacterial tests, respectively.
The microstructure of xAg/Ti-Ta SMAs was investigated using scanning electron microscopy (SEM), energy dispersive X-ray spectroscopy and X-ray diffraction (XRD). To evaluate the effect of Ag addition on the configuration of the pores, the shape, size and distribution were measured using Nikon optical microscopy attached to iSolution DT image analyzer. Archimedes drainage method was implemented to measure the sintered samples densities. The modified (xAg/Ti-30Ta) and unmodified (Ti-30Ta) alloys were also analyzed using a Siemens XRD-D5000 X-ray diffractometer equipped with a Cu-Kα source ray, using a locked mode, a scanning rate of 0.05°/s, and scanning angle (2θ) from 20°-90°.
The mechanical properties of the xAg/Ti-30Ta SMA were calculated with a 0.5 mm/min displacement speed at room temperature using a universal test machine (Instron 600 DX) representing compression and memory effect tests. The pseudoelasticity test was carried out at a particular strain value of 4% at 37 °C (Human body temperature) under the loading-unloading process.
The most common electrochemical technique used to examine the corrosion resistance of xAg/ Ti-Ta SMAs is potential polarisation (PDP) in a corrosive medium known simulated body fluid (SBF). The corrosion test was performed at the human body temperature of 37 °C through an open-air cell mode that was filled with a pH of 7.4 and a volume of 300 mL. The Tafel test was carried out at a scanning rate of 2 mV/s in the voltage range of -250 to 250 mV with an exposed surface area of 0.2 cm2. Data have been measured and recorded using a versaSTAT 3 machine (Princeton Applied Research). In order to ensure the replicability of the tests, every electrochemical experiment was replicated three times. The rate of corrosion (Ri) and polarization resistance (Rp) were measured according to Refs. [36, 37]:
Ri=22.85×Jcorr (1)
(2)
where βc is the cathodic Tafel slope; βa is the anodic Tafel slope;Jcorr is the corrosion current density. Eventually, the measurement accuracy was based on polarization curves xAg/Ti-Ta SMAs.
To calculate the antibacterial activity of Ti-30 at% Ta SMAs with and without the addition of Ag, an anti-disco diffusion to Escherichia coli bacteria was executed by gram-negative bacteria method [38]. The bacteria used were obtained from the Institute of Medical Research (IMR) in Kuala Lumpur. The glassware containing bacteria was sterilized for 20 min in an autoclave at 120 °C before the experiment was performed. A stock solution was developed by mixing 1 mL with 9 mL Luria–Bertani (LB) broth from each bacterial solution and incubated for 24 h at 37 °C and shake at 250 r/min, for each bacterium. Growing organism/bacteria were swabbed onto the disk (n=2) (1 to 108 mL-1) for the method of disk diffusion with the solidified agar nutrient media. Each platform has been incubated at 37 °C for 24 h. In this experiment, the image was filtered with a digital camera and repeated 3 times. The medium inhibition region that represented the biocompatibility of the alloys was established by the software of the image analyzer known as ImageJ (v 1.47).
3 Results and discussion
3.1 Microstructure characterization
Figures 1(a)-(d) display the optical micrographs of Ti-30 at% Ta SMAs with and without the addition of Ag. It was found that the average pore size decreases when adding 0.41 at% Ag and starts to increase with the further addition of Ag. The smallest pores with proper distribution were found in 0.41 Ag/Ti-Ta. The presence of irregular and uniform pores has also been found to improve the internal stress concentration and thus reduce mechanical and shape recovery characteristics by increasing the probability of crack propagation [39-41]. The modified (xAg/Ti-30Ta) SMAs have exhibited a small range of pore sizes from 2 to 25 μm, and the relative density (ρ/ρ0) was 70% to 72%. The average pore sizes of xAg/Ti-Ta (x is 0, 0.41 at%, 0.82 at%, and 2.48 at%) were (14±0.7) μm, (11±0.5) μm, (12.5±0.6) μm, and (14.48±0.7) μm, respectively. Two types of morphologies of (P) as plate-like and needle-like (N) structures are displayed in Figures 1(e)-(h), both of which are present in β-phase. Alternatively, there are other morphologies of β, such as needle-like, appearing as irregular lines or spaghetti (S) shape that contains the α-phase formed between these phases [42, 43]. The microstructure of Ti-Ta alloys’ surface shows two principal areas: the bright and dark regions, based on energy-dispersive spectroscopy (EDS). The bright region is the region of tantalum, and the dark area is the region of titanium [44-46]. Comparing the Ti-rich zone with the Ta-rich areas, the plate- and needle-like morphologies are much denser in Ti-rich zone. It was exhibited through high- resolution SEM that microscopic pores with high density were presented after the consolidation of the specimen. The macro-pore formed by the microwave-sintering process enables the growth and incorporation of bone tissue and implant in the porous xAg/Ti-Ta alloy [26, 47-49]. In addition, the shrinking pores in nanometers size can have a positive effect on cell proliferation and differentiation [50]. Figure 2 displays the elemental mapping of 0.82Ag/Ti-Ta SMAs. The first micrograph shows the mapping area and the distribution of Ti and Ta in the dark (Ti-rich) region and bright (Ta-rich) region. The distribution of Ag and O was very uniform in both Ti-rich and Ta-rich regions. The presence of Oxygen is not accurate due to the pores, filled with air, which gives incorrect results for O element [51]. Therefore, observation exhibits oxygen more than the real content.

Figure 1 Optical micrographs (a, b, c, d) and SEM micrographs (e, f, g, h) of xAg/Ti-Ta SMAs:
Figure 3 illustrates the XRD patterns of xAg/Ti-Ta SMAs, where the samples exhibited β and α phases along with compounds of Ag, TiAg, and AgTi3, and a few oxides of TiO2, Ag2O3, Ag2O, and Ta2O6 (this oxidization of the small intensities by argon gas during sintering may be caused by exposure to the atmosphere at 250-300 °C). The XRD scanning discloses crystalline peaking phases corresponding to a phase of β (Ti and Ta), which are indicated at 38.6°, 55.7°, 69.7° and 82.6°, respectively, on the lattice planes (110), (200), (211) and (220). In the direction of (100) and (101), the crystalline peaks corresponding to the α (Ti) cycle are aligned with 35.17° and 40.19°, respectively. The phase α (Ta) is observed at the plane (411) of an angle of 40.19°. The intensity of the peak at an angle of 38.6° was increased with the increasing of Ag addition to 0.41 at% and 0.82 at% Ag and reduced after increasing of Ag percentage to 2.48 at%. This increase in the β-phase improved the shape memory behaviour because of the transformation into the α″-phase via stress application [52]. The crystalline TiO2 peaks are matched to angles of 38.6°, 40.19°, 69.7° and 82.6°, respectively, in the direction of the lattice of (112), (022), (112) and (224). Meanwhile, the crystalline peak corresponding to the Ag2O observed at the lattice planes of (101) and (202) is matched to the angles of 38.6° and 82.6°, respectively. While the Ag2O3 that is observed at the lattice plane of (622) is matched to the angle of 69.7°, respectively; the Ta6O (β) was found at the plane (101) of angle 38.6°. Moreover, Ag, TiAg, and AgTi3 were observed at the plane (111) of angle 38.6° [13, 15, 53]. Mostly, these SMAs are austenitic alloys at room temperature.

Figure 2 Elemental mapping of 0.82 Ag/Ti- Ta SMAs

Figure 3 XRD patterns of xAg/Ti-Ta alloys
3.2 Mechanical properties
3.2.1 Stress-strain curves
Figure 4 demonstrates the stress-strain curves of xAg/Ti-Ta with different amounts of the Ag element. The values of elastic modulus of 0,0.41 at%, 0.82 at% and 2.48 at% Ag alloys samples were (7.2±0.4), (8.4±0.4), (6.5±0.3) and (6.49±0.3) GPa, respectively. The elastic modulus increased at 0.41 at% Ag and decreased after increasing the Ag content by more than this value. However, this low elastic modulus may be a response to the microwave-sintering process [24], and the porosity of these SMAs [24, 25]. This low elastic modulus is very important to diminish the effect of “stress shielding” [27-29]. The addition of the silver improves the fracture strength and strain. The fracture stress (strength property) and its strain of xAg/Ti-Ta SMAs with 0, 0.41 at%, 0.82 at% and 2.48 at% Ag were (375±19) MPa at (19.68±1)%, (493.6±25) MPa at (29.7±1.4)%, (450±23) MPa at (28.9±1.4)% and (363.7±18) MPa at (21±1)%, respectively. At 0.41 at% Ag/Ti-Ta alloy, the maximum fracture strength and strain were observed, due to several factors such as pores size and shape, pore distribution, composition, grain size, precipitate formation and degree of order. This SMA exhibits the smallest pore size average (11±0.5 μm) and the best distribution, indicating a suitable amount of Ag addition. The addition of the Ag element with an amount less than the range of Ti-Ag solubility prevents the presence of Ag precipitates, where, in the Ti-Ag phase diagram, it was observed that the Ti-Ag solubility is 2.48 at% [54-56].

Figure 4 Compressive curves of xAg/Ti-Ta alloys
3.2.2 Pseudoelastic recoverable strain
The β-phase to α″ martensitic phase transformation occurs primarily by employing the force per area during the process of loading and unloading within an α-martensitic phase (unstable phase) reverting mainly to β-austenitic phase [52]. A specifically designed compression test at temperature below Ms was used to determine the total strain recovery of Ti-Ta SMAs before and after the adding of Ag. This cognitive behaviour correlated with the martensitic transition from β to α''can be a reason for getting good type of memory behavior for these SMAs. The total strain recovery (εT) varied with the changes in the amount of Ag (see Figure 5). It was clearly shown that the addition of Ag with different percentage resulted in strain recovery increment. With 0.41 at% Ag alloy showed the highest εT after the preheating process at T>Af. In addition, the εT increased from 37.36% to 47.076%. The εT is decreased with the increase of Ag additions more than 0.41 at%. The εT values of the SMAs at 0.82 at% Ag and 2.48 at% Ag were 45.251% and 42.1%, respectively. This reduction in εT may be due to several considerations, such as Ag precipitates formed due to adding Ag more than the 2.48 at% (as mentioned above) [54-56]. And it was also recommended that the increase in the amount of Ag add-ons leads to heightening the stability of α-phase. The residual strain (εR) values of these SMAs at x=0, 0.41 at%, 0.82 at% and 2.48 at% Ag were (2.5053±0.12)%, (2.1169±0.1)%, (2.1899± 0.1)% and (2.3159± 0.11)%, respectively. Table 1 displays the residual strain and εT of Ag/Ti-Ta SMAs at 37 °C. Figure 5(e) shows the loading- unloading test of 0.82 Ag/Ti-Ta SMA with three cycles of the same SMA in Figure 5(c) at the same strain. The first cycle exhibits lower strain recovery compared to the next two loading-unloading cycles. This first cycle in Figure 5(e) considers the second loading-unloading of the sample in Figure 5(c) after disconnecting from the compression machine. The disconnecting of this sample leaves some residual strain which caused higher stress, and better recovery, and the density of the dislocations increases after the second loading-unloading of the same sample (Figure 5(c)) which caused better recovery [57]. The repeating of the loading- unloading (without disconnecting the sample from the compression machine) causes fully recovery (cycle 2 and cycle 3), as YUAN et al [58] reported that for the first cycle of any sequence, some plastic deformation accumulates as a result of “shakedown” but after that the plastic residual deformation is minimal with 98%-99% recovery rates. The sample in Figure 5(c) chosen for the multi-cycle test is due to the obvious plastic deformation region. While it was reported by LOBODYUK et al [57] that after 3-4 cycles the recoverable strain increases from 20% to 60%, due to the hardening of the parent phase as a result of increasing of density of dislocations arising during cycling, after the first cycle some residual strain is preserved [59]. However, during subsequent cycles of “loading-unloading”, the behaviour of Ti-alloys is different, and full recovery is observed after 3 cycles [57, 60]. However, the initial phase state of Ti-alloys is almost the same: at room temperature β-phase as the main phase.
3.3 Corrosion behavior
Figure 6 shows the electrochemical effects of the xAg/Ti-Ta SMAs. The Ti-30 at%Ta corrosion potential (Ecorr) was -133417 mV, and the Ecorr was increased after Ag was added. The Jcorr analysis of the binary Ti-30Ta and ternary Ag/Ti-30Ta SMAs showed less satisfactory corrosion behavior with a high corrosion rate (Ri) and the lowest polarization resistance (Rp) of 2.48 at% Ag/Ti-30 at% Ta SMA.Compared with the other alloys with or without Ag incorporated, this alloy had the highest corrosion current. Moreover, 0.41 at% Ag/Ti-Ta SMA shows the highest polarisation resistance of 6.364 kΩ and the lowest corrosion rate of 0.2808 mm/year. Table 2 displays the electrochemical parameters of xAg/Ti-Ta SMAs. CHEN et al [21] described that the additions of fine particles of Ag element to pure Ti decreased the corrosion rate if this element was added in small amounts. However, with a further increase of Ag to 0.82 at% can cause an increase of corrosion rate. It was also reported that adding tantalum with different amounts enhances the biocompatibility and corrosion resistance of Ti and its related alloys [61, 62].

Figure 5 Stress-strain curves and shape recovery of:
Table 1 Residual strain and total strain recovery of xAg/Ti-Ta SMAs at 37 °C


Figure 6 Potentiodynamic polarisation curves xAg/Ti-Ta SMAs
Table 2 Electrochemical parameters of xAg/Ti-30Ta SMAs in SBF solution obtained from polarization test

3.4 Antibacterial test
Figure 7 shows the bioactivities results as the inhibition zone of the xAg/Ti-30Ta SMAs versus E.coli bacteria. The inhibition zones averages for xAg/Ti-30Ta were (2.7±0.14) mm, (2.87±0.14) mm, (3.5±0.18) mm, and (6.4±0.3) mm against E. coli for x=0, 0.41 at%, 0.82 at% and 2.48 at% Ag, respectively. The inhibition zones were increased with the increase of silver additions. In addition, the Ti-Ta SMA exhibits an irregular inhibition zone that became more uniform against E. coli after adding silver. In Refs. [22, 63], the antibacterial function/ mechanism of Ag was demonstrated. The Ag ions interact with the bacterial enzymes and proteins, causing structural damage to the bacterial membrane and cell wall, as that Ag ions were suggested to prevent bacterial reproduction [22]. Several studies mentioned the good antibacterial effect of TiO2, especially in the presence of silver [64-66]. In addition, the Ta and Ta oxide coatings were used to enhance the antibacterial and biological effects of the Ti surface [67-69]. Another study combined the Ta-oxide coating layers with silver to improve the antibacterial activity of Ta-oxide coating [70]. Increasing the silver content as well as using fine Ag particle sizes with proper distribution improved the antibacterial properties [21, 22]. Many studies have shown that Ag particles and their compound have nano- and micro-effects due to their ability to suppress bacteria growth and other microorganisms, such as viruses, Fungi, and Yeast [71-74], that can be triggered by the creation of a large area or a contact interface with bacteria [71, 75]. Although many kinds of literatures show that there are superior antibacterial properties of silver-based materials, the control mechanism remains unclear. However, it well known that the releasing of Ag+ ions into the materials may obtain a vital role on the permeability of cell membrane and thus reduce the driving force of proton, including damaging DNA replication and disruption of the phosphate cell de-energization and efflux leading to cell content leakage [71].
Figure 7 Inhibition zones of:
4 Conclusions
We have succeeded in producing porous xAg/ Ti-30Ta SMAs using microwave-sintering technology. Silver additions have been reported for the microstructure, composition of phases, temperature of phase transformation, mechanical property, SMEs, bio-corrosion, and bioactivity of the as-synthesized alloys. The xAg/Ti-30Ta SMAs are shown to be a needle-like (β) and a plate-like (β). There are two stages: β (primary stage) and α (secondary phase), but these are the two phases of microstructure. These alloys are α martensitic when stress is applied due to β-phase to the α"-phase transformation that improves the recovery behaviour. The mechanical, chemical and biological properties were enhanced by adding 0.41 at% Ag, and the increase of Ag content more than this percentage reduces the fracture strength and strain, strain recovery, and bio-corrosion. The antibacterial effect was enhanced gradually by increasing the Ag content, and the largest inhibition zone was at 2.48 at% Ag (6.4±0.3 mm). A basis to produce Ti-30Ta SMAs with a satisfactory biocompatible quality may be our systematic method, specimen preparation, additions, and characterization.
Contributors
The concept and objectives of this research were developed by Mustafa Khaleel IBRAHIM, Safaa Najah SAUD, Esah HAMZAH and Engku Mohamad NAZIM. Mustafa Khaleel IBRAHIM provided the measurement of the mechanical and microstructure investigation and analysis of the measured data was carried out by Safaa Najah SAUD. Part of the analysis facts and their relation to the obtained results were interpreted by Esah HAMZAH and Engku Mohamad NAZIM. The initial draft of the manuscript was written by Mustafa Khaleel IBRAHIM and modified by Safaa Najah SAUD. All the authors were contributed in replying to reviewers’ comments and revising of the final version.
Conflict of interest
Mustafa Khaleel IBRAHIM, Safaa Najah SAUD, Esah HAMZAH, Engku Mohamad NAZIM declare that they have no conflict of interest.
References
[1] BIESIEKIERSKI A, WANG J, ABDEL-HADY GEPREEL M, WEN Cui-e. A new look at biomedical Ti-based shape memory alloys [J]. Acta Biomaterialia, 2012, 8(5): 1661- 1669.
[2] MIYAZAKI S, KIM H Y, HOSODA H. Development and characterization of Ni-free Ti-base shape memory and superelastic alloys [J]. Materials Science and Engineering A, 2006, 438-440: 18-24.
[3] WEVER D J, VELDHUIZEN A G, SANDERS M M, SCHAKENRAAD J M, van HORN J R. Cytotoxic, allergic and genotoxic activity of a nickel-titanium alloy [J]. Biomaterials, 1997, 18(16): 1115-1120.
[4] NIINOMI M. Fatigue performance and cyto-toxicity of low rigidity titanium alloy, Ti–29Nb–13Ta–4.6Zr [J]. Biomaterials, 2003, 24(16): 2673-2683.
[5] LAHEURTE P, PRIMA F, EBERHARDT A, GLORIANT T, WARY M, PATOOR E. Mechanical properties of low modulus β titanium alloys designed from the electronic approach [J]. Journal of the Mechanical Behavior of Biomedical Materials, 2010, 3(8): 565-573.
[6] NING Cong-qin, ZHOU Yu. Development and research status of biomedical titanium alloys [J]. Material Science and Technology, 2002, 10(1): 100-106. (in Chinese)
[7] FUKUI Y, INAMURA T, HOSODA H, WAKASHIMA K, MIYAZAKI S. Mechanical properties of a Ti-Nb-Al shape memory alloy [J]. Materials Transactions, 2004, 45(4): 1077-1082.
[8] KIM H Y, HASHIMOTO S, KIM J I, HOSODA H, MIYAZAKI S. Mechanical properties and shape memory behavior of Ti-Nb alloys [J]. Materials Transactions, 2004, 45(7): 2443-2448.
[9] KIM H Y, OHMATSU Y, KIM J I, HOSODA H, MIYAZAKI S. Mechanical properties and shape memory behavior of Ti-Mo-Ga alloys [J]. Materials Transactions, 2004, 45(4): 1090-1095.
[10] MAESHIMA T, NISHIDA M. Shape memory properties of biomedical Ti-Mo-Ag and Ti-Mo-Sn alloys [J]. Materials Transactions, 2004, 45(4): 1096-1100.
[11] DUERIG T W, ALBRECHT J, RICHTER D, FISCHER P. Formation and reversion of stress induced martensite in Ti-10V-2Fe-3Al [J]. Acta Metallurgica, 1982, 30(12): 2161-2172.
[12] BAHADOR A, HAMZAH E, KONDOH K, ABU BAKAR T A, YUSOF F, IMAI H, SAUD S N, IBRAHIM M K. Effect of deformation on the microstructure, transformation temperature and superelasticity of Ti-23 at% Nb shape- memory alloys [J]. Materials & Design, 2017, 118: 152-162.
[13] BUENCONSEJO P J S, KIM H Y, HOSODA H, MIYAZAKI S. Shape memory behavior of Ti–Ta and its potential as a high-temperature shape memory alloy [J]. Acta Materialia, 2009, 57(4): 1068-1077.
[14] MA Yun-qing, YANG Shui-yuan, JIN Wan-jun, WANG Yun-neng, WANG Cui-ping, LIU Xing-jun. Microstructure, mechanical and shape memory properties of Ti-55Ta-xSi biomedical alloys [J]. Transactions of Nonferrous Metals Society of China, 2011, 21(2): 287-291.
[15] ZHOU Y L, NIINOMI M, AKAHORI T. Effects of Ta content on Young’s modulus and tensile properties of binary Ti–Ta alloys for biomedical applications [J]. Materials Science and Engineering A, 2004, 371(1, 2): 283-290.
[16] MARECI D, CHELARIU R, GORDIN D M, UNGUREANU G, GLORIANT T. Comparative corrosion study of Ti–Ta alloys for dental applications [J]. Acta Biomaterialia, 2009, 5(9): 3625-3639.
[17] KIM H Y, FUKUSHIMA T, BUENCONSEJO P J S, NAM T H, MIYAZAKI S. Martensitic transformation and shape memory properties of Ti–Ta–Sn high temperature shape memory alloys [J]. Materials Science and Engineering A, 2011, 528(24): 7238-7246.
[18] IKEDA M, KOMATSU S Y, NAKAMURA Y. Effects of Sn and Zr additions on phase constitution and aging behavior of Ti-50 mass%Ta alloys quenched from β single phase region [J]. Materials Transactions, 2004, 45(4): 1106-1112.
[19] IBRAHIM M K, SAUD S N, HAMZAH E, NAZIM E M. Shape memory characteristics of microwave sintered porous Ti–30 at.%Ta alloy for biomedical applications [J]. Proceedings of the Institution of Mechanical Engineers, Part C: Journal of Mechanical Engineering Science, 2020, 234(10): 1979-1989.
[20] BAHADOR A, KARIYA S, UMEDA J, HAMZAH E, KONDOH K. Tailoring microstructure and properties of a superelastic Ti–Ta alloy by incorporating spark plasma sintering with thermomechanical processing [J]. Journal of Materials Engineering and Performance, 2019, 28(5): 3012-3020.
[21] CHEN Mian, ZHANG Er-lin, ZHANG Lan. Microstructure, mechanical properties, bio-corrosion properties and antibacterial properties of Ti–Ag sintered alloys [J]. Materials Science and Engineering C, 2016, 62: 350-360.
[22] LI Wen-ru, XIE Xiao-bao, SHI Qing-shan, ZENG Hai-yan, OUYANG You-sheng, CHEN Yi-ben. Antibacterial activity and mechanism of silver nanoparticles on Escherichia coli [J]. Applied Microbiology and Biotechnology, 2010, 85(4): 1115-1122.
[23] ZHENG Y F, ZHANG B B, WANG B L, WANG Y B, LI L, YANG Q B, CUI L S. Introduction of antibacterial function into biomedical TiNi shape memory alloy by the addition of element Ag [J]. Acta Biomaterialia, 2011, 7(6): 2758-2767.
[24] XU J L, BAO L Z, LIU A H, JIN X J, TONG Y X, LUO J M, ZHONG Z C, ZHENG Y F. Microstructure, mechanical properties and superelasticity of biomedical porous NiTi alloy prepared by microwave sintering [J]. Materials Science and Engineering C, 2015, 46: 387-393.
[25] YANG Dong-hua, GUO Zhi-meng, SHAO Hui-ping, LIU Xiao-ting, JI Ye. Mechanical properties of porous Ti-Mo and Ti-Nb alloys for biomedical application by gelcasting [J]. Procedia Engineering, 2012, 36: 160-167.
[26] MOUR M, DAS D, WINKLER T, HOENIG E, MIELKE G, MORLOCK M M, SCHILLING A F. Advances in porous biomaterials for dental and orthopaedic applications [J]. Materials, 2010, 3(5): 2947-2974.
[27] GEETHA M, SINGH A K, ASOKAMANI R, GOGIA A K. Ti based biomaterials, the ultimate choice for orthopaedic implants – A review [J]. Progress in Materials Science, 2009, 54(3): 397-425.
[28] NAGELS J, STOKDIJK M, ROZING P M. Stress shielding and bone resorption in shoulder arthroplasty [J]. Journal of Shoulder and Elbow Surgery, 2003, 12(1): 35-39.
[29] NIINOMI M. Metallic biomaterials [J]. Journal of Artificial Organs, 2008, 11(3): 105-110.
[30] HEY J C, JARDINE A P. Shape memory TiNi synthesis from elemental powders [J]. Materials Science and Engineering A, 1994, 188(1, 2): 291-300.
[31] GREEN S M, GRANT D M, KELLY N R. Powder metallurgical processing of Ni–Ti shape memory alloy [J]. Powder Metallurgy, 1997, 40(1): 43-47.
[32] MORRIS D G, MORRIS M A. NiTi intermetallic by mixing, milling and interdiffusing elemental components [J]. Materials Science and Engineering A, 1989, 110: 139-149.
[33] VAJPAI S K, DUBE R K, SANGAL S. Application of rapid solidification powder metallurgy processing to prepare Cu–Al–Ni high temperature shape memory alloy strips with high strength and high ductility [J]. Materials Science and Engineering A, 2013, 570: 32-42.
[34] PORTIER R A, OCHIN P, PASKO A, MONASTYRSKY G E, GILCHUK A V, KOLOMYTSEV V I, KOVAL Y N. Spark plasma sintering of Cu-Al-Ni shape memory alloy [J]. Journal of Alloys and Compounds, 2013, 577: S472-S477.
[35] OGHBAEI M, MIRZAEE O. Microwave versus conventional sintering: A review of fundamentals, advantages and applications [J]. Journal of Alloys and Compounds, 2010, 494(1, 2): 175-189.
[36] BAKHSHESHI-RAD H R, IDRIS M H, ABDUL-KADIR M R, OURDJINI A, MEDRAJ M, DAROONPARVAR M, HAMZAH E. Mechanical and bio-corrosion properties of quaternary Mg-Ca-Mn-Zn alloys compared with binary Mg-Ca alloys [J]. Materials & Design, 2014, 53: 283-292.
[37] ARGADE G R, KANDASAMY K, PANIGRAHI S K, MISHRA R S. Corrosion behavior of a friction stir processed rare-earth added magnesium alloy [J]. Corrosion Science, 2012, 58: 321-326.
[38] IQBAL N, ABDUL KADIR M R, BIN MAHMOOD N H, IQBAL S, ALMASI D, NAGHIZADEH F, BALAJI H R, KAMARUL T. Characterization and biological evaluation of silver containing fluoroapatite nanoparticles prepared through microwave synthesis [J]. Ceramics International, 2015, 41(5): 6470-6477.
[39] KIM Y W, LEE Y J, NAM T H. Shape memory characteristics of Ti–Ni–Mo alloys sintered by Sparks plasma sintering [J]. Journal of Alloys and Compounds, 2013, 577: S205-S209.
[40] XU J L, BAO L Z, LIU A H, JIN X F, LUO J M, ZHONG Z C, ZHENG Y F. Effect of pore sizes on the microstructure and properties of the biomedical porous NiTi alloys prepared by microwave sintering [J]. Journal of Alloys and Compounds, 2015, 645: 137-142.
[41] BECKER W, LAMPMAN S. Fracture appearance and mechanisms of deformation and fracture [M] Failure Analysis and Prevention. ASM International, 2002: 559-586.
[42] HON Y H, WANG J Y, PAN Y N. Composition/phase structure and properties of titanium-niobium alloys [J]. Materials Transactions, 2003, 44(11): 2384-2390.
[43] HAN M K, KIM J Y, HWANG M J, SONG H J, PARK Y J. Effect of Nb on the microstructure, mechanical properties, corrosion behavior, and cytotoxicity of Ti-Nb alloys [J]. Materials, 2015, 8(9): 5986-6003.
[44] NAIDOO M, JOHNSON O, SIGALAS I, HERRMANN M. Preparation of Ti-Ta-(C, N) by mechanical alloying Ti(C, N) and TaC [J]. International Journal of Refractory Metals and Hard Materials, 2013, 37: 67-72.
[45] LIU Yong, LI Kai-yang, WU Hong, SONG Min, WANG Wen, LI Nian-feng, TANG Hui-ping. Synthesis of Ti-Ta alloys with dual structure by incomplete diffusion between elemental powders [J]. Journal of the Mechanical Behavior of Biomedical Materials, 2015, 51: 302-312.
[46] NAIDOO M, RAETHEL J, SIGALAS I, HERRMANN M. Preparation of (Ti, Ta)–(C, N) by mechanical alloying [J]. International Journal of Refractory Metals and Hard Materials, 2012, 35: 178-184.
[47] AKIN F A, ZREIQAT H, JORDAN S, WIJESUNDARA M B J, HANLEY L. Preparation and analysis of macroporous TiO2 films on Ti surfaces for bone-tissue implants [J]. Journal of Biomedical Materials Research, 2001, 57(4): 588-596.
[48] BANSIDDHI A, SARGEANT T D, STUPP S I, DUNAND D C. Porous NiTi for bone implants: A review [J]. Acta Biomaterialia, 2008, 4(4): 773-782.
[49] RYAN G, PANDIT A, APATSIDIS D. Fabrication methods of porous metals for use in orthopaedic applications [J]. Biomaterials, 2006, 27(13): 2651-2670.
[50] GITTENS R A, MCLACHLAN T, OLIVARES- NAVARRETE R, CAI Y, BERNER S, TANNENBAUM R, SCHWARTZ Z, SANDHAGE K H, BOYAN B D. The effects of combined micron-/submicron-scale surface roughness and nanoscale features on cell proliferation and differentiation [J]. Biomaterials, 2011, 32(13): 3395-3403.
[51] WASSILKOWSKA A, CZAPLICKA-KOTAS A, BIELSKI A, ZIELINA M. An analysis of the elemental composition of micro-samples using EDS technique [J] Czasopismo Techniczne, 2015, 2014: 133-148.
[52] KOLLI R P, JOOST W J, ANKEM S. Phase stability and stress-induced transformations in beta titanium alloys [J]. JOM, 2015, 67(6): 1273-1280.
[53] WEN Ming, WEN Cui-e, HODGSON P D, LI Yun-cang. Mechanical property and microstructure of Ti-Ta-Ag alloy for biomedical applications [J]. Key Engineering Materials, 2012, 520: 254-259.
[54] DAVIES R H, DINSDALE A T, GISBY J A, ROBINSON J, MARTIN S M. MTDATA - thermodynamic and phase equilibrium software from the national physical laboratory [J]. Calphad, 2002, 26(2): 229-271.
[55] MORINAGA T, MIURA I, TAKAAI T. On the phase diagram of the titanium-silver system [J]. Journal of the Japan Institute of Metals and Materials, 1959, 23(2): 117-121.
[56] EREMENKO V N, BUYANOV Y I, PANCHENKO N M. Constitution diagram of the system titanium-silver [J]. Soviet Powder Metallurgy and Metal Ceramics, 1969, 8(7): 562-566.
[57] LOBODYUK V A. Reversibility of the martensitic transformations and shape-memory effects [J]. Uspehi Fiziki Metallov, 2016, 17(2): 89-118.
[58] YUAN Bin, ZHENG Pei-qi, GAO Yan, ZHU Min, DUNAND D C. Effect of directional solidification and porosity upon the superelasticity of Cu–Al–Ni shape- memory alloys [J]. Materials & Design, 2015, 80: 28-35.
[59] PROKOSHKIN S, BRAILOVSKI V, PETRZHIK M, FILONOV M R, SHEREMETYEV V. Mechanocyclic and time stability of the loading-unloading diagram parameters of nanostructured Ti-Nb-Ta and Ti-Nb-Zr SMA [J]. Materials Science Forum, 2013, 738-739: 481-485.
[60] SAEDI S. Shape memory behavior of dense and porous NiTi alloys fabricated by selective laser melting [M]. US: University of Kentucky, 2017.
[61] ZHOU Ying-long, NIINOMI M, AKAHORI T, NAKAI M, FUKUI H. Comparison of various properties between titanium-tantalum alloy and pure titanium for biomedical applications [J]. Materials Transactions, 2007, 48(3): 380-384.
[62] ZHOU Ying-long, NIINOMI M, AKAHORI T, FUKUI H, TODA H. Corrosion resistance and biocompatibility of Ti–Ta alloys for biomedical applications [J]. Materials Science and Engineering A, 2005, 398(1, 2): 28-36.
[63] IQBAL N, KADIR M R A, MAHMOOD N H, SALIM N, FROEMMING G R A, BALAJI H R, KAMARUL T. Characterization, antibacterial and in vitro compatibility of zinc-silver doped hydroxyapatite nanoparticles prepared through microwave synthesis [J]. Ceramics International, 2014, 40(3): 4507-4513.
[64] GUPTA K, SINGH R P, PANDEY A, PANDEY A. Correction: Photocatalytic antibacterial performance of TiO2 and Ag-doped TiO2 against S. aureus. P. aeruginosa and E. coli [J]. Beilstein Journal of Nanotechnology, 2020, 11: 547-549.
[65] KUBACKA A, DIEZ M S, ROJO D, BARGIELA R, CIORDIA S, ZAPICO I, ALBAR J P, BARBAS C, MARTINS DOS SANTOS V A P. Understanding the antimicrobial mechanism of TiO2-based nanocomposite films in a pathogenic bacterium [J]. Scientific Reports, 2015, 4: 4134.
[66] LU Yun, HAO Lian, HIRAKAWA Y, SATO H. Antibacterial activity of TiO2/Ti composite photocatalyst films treated by ultrasonic cleaning [J]. Advances in Materials Physics and Chemistry, 2012, 2(4): 9-12.
[67] CHANG Yin-yu, HUANG Heng-li, CHEN Hung-jui, LAI Chih-ho, WEN Chi-yuan. Antibacterial properties and cytocompatibility of tantalum oxide coatings [J]. Surface and Coatings Technology, 2014, 259: 193-198.
[68] SUN Ying-sui, CHANG J H, HUANG H H. Using submicroporous Ta oxide coatings deposited by a simple hydrolysis–condensation process to increase the biological responses to Ti surface [J]. Surface and Coatings Technology, 2014, 259: 199-205.
[69] MENG Fan-hao, LI Zi-hui, LIU Xuan-yong. Synthesis of tantalum thin films on titanium by plasma immersion ion implantation and deposition [J]. Surface and Coatings Technology, 2013, 229: 205-209.
[70] CAO Hui-liang, MENG Fan-hao, LIU Xuan-yong. Antimicrobial activity of tantalum oxide coatings decorated with Ag nanoparticles [J]. Journal of Vacuum Science & Technology A: Vacuum, Surfaces, and Films, 2016, 34(4): 04C102.
[71] MARAMBIO-JONES C, HOEK E M V. A review of the antibacterial effects of silver nanomaterials and potential implications for human health and the environment [J]. Journal of Nanoparticle Research, 2010, 12(5): 1531-1551.
[72] JANARDHANAN R, KARUPPAIAH M, HEBALKAR N, RAO T N. Synthesis and surface chemistry of nano silver particles [J]. Polyhedron, 2009, 28(12): 2522-2530.
[73] NECULA B S, VAN LEEUWEN J P T M, FRATILA- APACHITEI L E, ZAAT S A J, APACHITEI I, DUSZCZYK J. In vitro cytotoxicity evaluation of porous TiO2–Ag antibacterial coatings for human fetal osteoblasts [J]. Acta Biomaterialia, 2012, 8(11): 4191-4197.
[74] LEE D, COHEN R E, RUBNER M F. Antibacterial properties of Ag nanoparticle loaded multilayers and formation of magnetically directed antibacterial microparticles [J]. Langmuir, 2005, 21(21): 9651-9659.
[75] REIDY B, HAASE A, LUCH A, DAWSON K, LYNCH I. Mechanisms of silver nanoparticle release, transformation and toxicity: a critical review of current knowledge and recommendations for future studies and applications [J]. Materials, 2013, 6(6): 2295-2350.
(Edited by ZHENG Yu-tong)
中文导读
银对多孔Ti-30 at%Ta形状记忆合金的微观结构、力学性能、腐蚀行为和生物相容性的影响
摘要:本文采用粉末冶金技术和微波烧结工艺制备了xAg/Ti-Ta。采用光学和扫描电子显微镜(SEM)、X射线衍射仪(XRD)、压缩试验和形状记忆试验研究了xAg/Ti-30Ta (x=0, 0.41 at%, 0.82 at%和2.48 at%)形状记忆合金(SMAs)的热力学、力学和生物性能。结果表明,Ag的加入对颗粒的孔径和形状有显著影响,在Ag加入量为0.41 at%时,颗粒的最小孔径为11 μm,相对密度为72%。断裂应力和应变随着Ag的增加而增加,Ag加入量为0.41 at%的合金断裂应力应变达到最大。0.82 at% Ag/Ti-Ta表现出更好的耐蚀性和生物相容性,具有与纯Ti和Ti6Al4V合金类似的性能,具备作为生物材料的应用前景。
关键词:多孔xAg / Ti-Ta合金;形状记忆合金;微波烧结工艺;微观结构特征;为学性能和腐蚀行为;生物活性
Foundation item: Project(Q. J130000.2524.12H60) supported by the Ministry of Higher Education of Malaysia and Universiti Teknologi Malaysia
Received date: 2020-03-22; Accepted date: 2020-06-12
Corresponding author: Esah HAMZAH, PhD, Professor; E-mail: esah@mail.fkm.utm.my; ORCID: https://orcid.org/0000-0003-1455- 1957